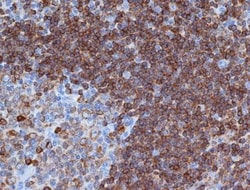
CD79A Mouse anti-Human, Mouse, Rat, Porcine, Bovine, Canine, Chicken, Equine,

missing translation for 'onlineSavingsMsg'
Learn More
Learn More
CD79A Mouse anti-Human, Mouse, Rat, Porcine, Bovine, Canine, Chicken, Equine, Guinea Pig, Goat, Ferret, Monkey, Rabbit, Clone: HM57, Novus Biologicals™
Mouse Monoclonal Antibody has been used in 1 publication
Marca: Novus Biologicals NB100-64347

Este artículo no se puede devolver.
Vea la política de devoluciones
Descripción
CD79A Monoclonal specifically detects CD79A in Human, Mouse, Rat, Porcine, Bovine, Canine, Chicken, Equine, Guinea Pig, Goat, Ferret, Monkey, Rabbit samples. It is validated for Flow Cytometry, Immunohistochemistry, Immunocytochemistry/Immunofluorescence, Immunohistochemistry-Paraffin, Immunohistochemistry-Frozen.Especificaciones
| CD79A | |
| Monoclonal | |
| 1.0 mg/mL | |
| Flow Cytometry 1:50-1:100, Immunohistochemistry 1:10-1:500, Immunocytochemistry/Immunofluorescence 1:10-1:500, Immunohistochemistry-Paraffin 1:100-1:500, Immunohistochemistry-Frozen 1:10-1:500 | |
| P11912 | |
| CD79A | |
| Synthetic peptide corresponding to 202-216 amino acid sequence of human mb-1. | |
| 0.1 mg | |
| Primary | |
| NB100-64347 recognizes an epitope within the cytoplasmic domain of CD79a. CD79a, also known as mb-1, is a 45kD protein that is expressed by B lymphocytes during differentiation from early pre-B cell stage through to plasma cells. The CD79a molecule associates with CD79b (B29) to form a heterodimer that is non-covalently linked to surface immunoglobulin, forming the B-cell receptor (BCR) complex. The CD79a/CD79b heterodimers are also necessary for intracellular signalling following antigen-binding to surface immunoglobulin. Clone HM57 has been reported to work in western blotting applications. | |
| Store at 4C short term. Aliquot and store at -20C long term. Avoid freeze-thaw cycles. | |
| IgG1 |
| Flow Cytometry, Immunohistochemistry, Immunocytochemistry, Immunofluorescence, Immunohistochemistry (Paraffin) | |
| HM57 | |
| Unconjugated | |
| Phosphate buffered saline with 0.09% Sodium Azide | |
| CD79a antigen, CD79A antigen (immunoglobulin-associated alpha), CD79a molecule, immunoglobulin-associated alpha, IGAB-cell antigen receptor complex-associated protein alpha chain, Ig-alpha, MB1, MB-1, MB-1 membrane glycoprotein, Membrane-bound immunoglobulin-associated protein, Surface IgM-associated protein | |
| Mouse | |
| Protein G purified | |
| RUO | |
| 973 | |
| Human, Mouse, Rat, Porcine, Bovine, Canine, Chicken, Equine, Guinea Pig, Goat, Ferret, Monkey, Rabbit | |
| Purified |
Título del producto
Al hacer clic en Enviar, acepta que Fisher Scientific se ponga en contacto con usted en relación con los comentarios que ha proporcionado en este formulario. No compartiremos su información para ningún otro fin. Toda la información de contacto proporcionada se mantendrá de acuerdo con nuestra Política de Privacidad. Política de privacidad.
¿Detecta una oportunidad de mejora?
For Research Use Only
-Flow-Cytometry-NB100-64347-img0003.jpg-250.jpg)
-Immunohistochemistry-NB100-64347-img0005.jpg-250.jpg)